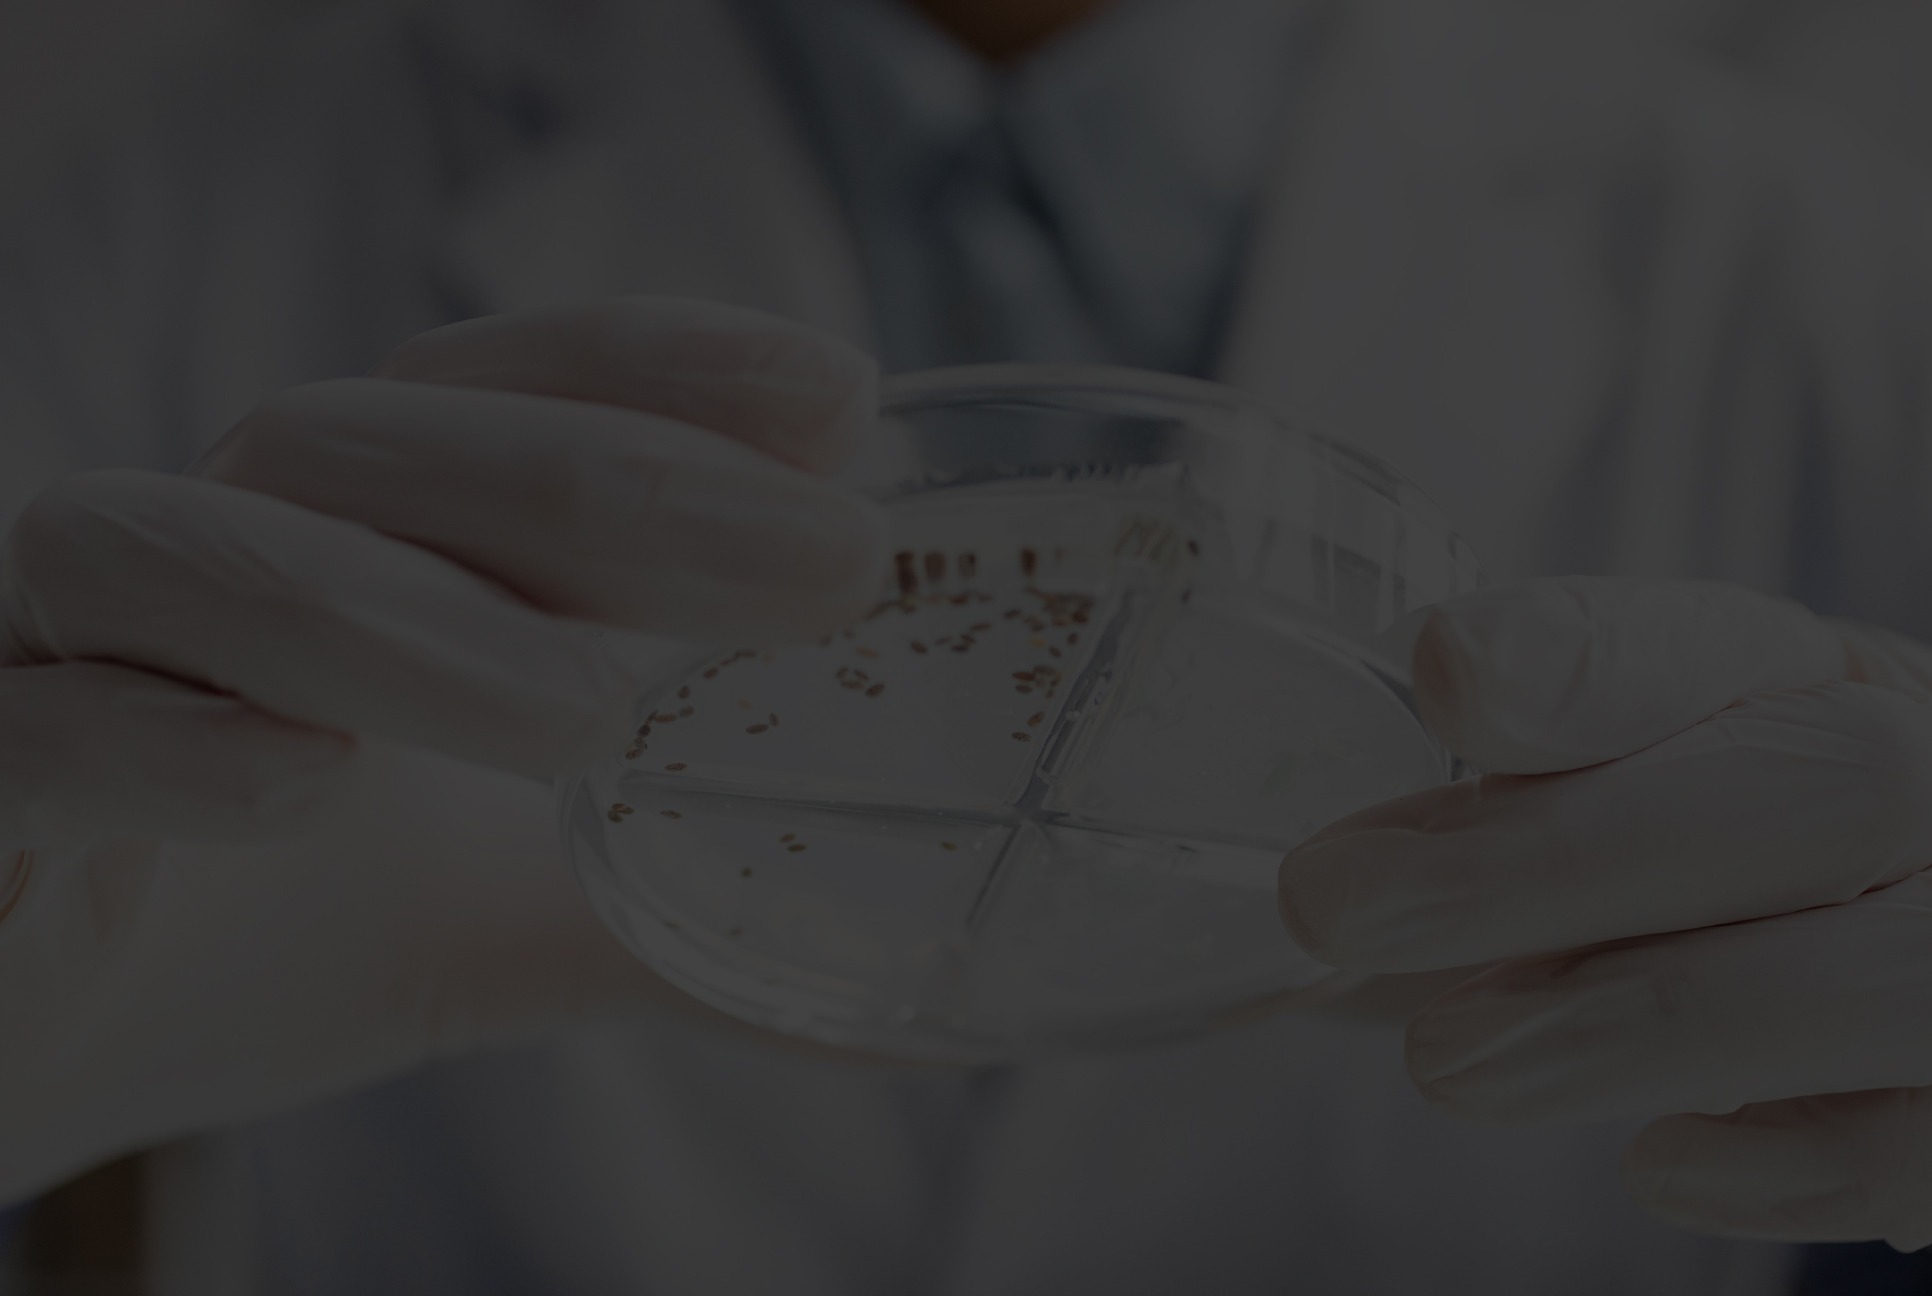

Plant-Based
Functional Nutrition
for Healthy Aging & Better Living
โภชนาการจากพืชที่ออกแบบเพื่อการดูแลสุขภาพระยะยาว
Why Nutrition Matters As We Age

ดูแลโภชนาการ
เพื่อสุขภาพระยะยาว

สนับสนุนการดูแล
มวลกล้ามเนื้อในทุกช่วงวัย

โปรตีนจากพืช
ย่อยง่าย

สร้างสุขภาพที่ดี
ได้ในทุกวัน

เมื่ออายุมากขึ้นร่างกายต้องการการดูแลด้านโภชนาการที่เหมาะสมมากขึ้น โดยเฉพาะการได้รับโปรตีนอย่างเพียงพอในแต่ละวัน
AlmaPro ได้รับการออกแบบในแนวคิด Plant-Based Functional Nutrition
“เพื่อสนับสนุนการดูแลสุขภาพในระยะยาวและคุณภาพชีวิตที่ดีในทุกช่วงวัย”


โปรตีนจากพืชคุณภาพ
ย่อยง่าย อ่อนโยน
ต่อร่างกาย

ส่วนประกอบสำคัญ
และจำเป็นต่อร่างกาย

สร้างสุขภาพที่ดีอย่างยั่งยืน
ด้วยโภชนาการที่สมดุล

ดูแลสุขภาพในทุกช่วงวัย
เพื่อคุณภาพชีวิตที่ดีในระยะยาว

สนับสนุนการได้รับ
โปรตีนที่เหมาะสม
ในชีวิตประจำวัน
มีใยอาหาร
ช่วยดูแลระบบ
ทางเดินอาหาร
สูตรโซเดียมต่ำ
ใส่ใจสุขภาพหัวใจ
ไม่มีนม ไม่มีน้ำตาล
เป็นมิตรต่อสุขภาพ
การดูแลสุขภาพที่ดีที่สุด
คือการสร้างนิสัยที่ดีในทุกวัน
เพื่ออนาคตที่คุณจะมีความสุข
กับชีวิตได้อย่างยาวนาน

โปรตีน
AlmaPro โปรตีนพืช | Intensive Regeneration Program โปรแกรมดูแลเข้มข้น สำหรับการเปลี่ยนแปลงระยะยาว

หนึ่งในองค์ประกอบสำคัญของโภชนาการคือ “โปรตีน” ซึ่งเป็นสารอาหารจำเป็นที่มีบทบาทต่อการทำงานของร่างกายในหลายระบบ
ตั้งแต่การสร้างกล้ามเนื้อ การฟื้นฟูเนื้อเยื่อ ไปจนถึงการสนับสนุนกระบวนการทางชีวภาพต่าง ๆ
และในช่วงหลายปีที่ผ่านมา Plant-Based Protein หรือ “โปรตีนจากพืช” ได้รับความสนใจมากขึ้นในกลุ่มผู้ที่ใส่ใจสุขภาพระยะยาว
หรือผู้ที่รับประทานอาหารแนว Wellness และผู้ที่ให้ความสำคัญกับ Healthy Aging
Plant-Based Protein คือแหล่งโปรตีนที่ได้จากพืช เช่น
🌱 Pea Protein
🌱 Soy Protein
🌱 Brown Rice Protein
🌱 Pumpkin Seed Protein
โปรตีนเหล่านี้สามารถนำมาสกัดหรือผสมร่วมกันเพื่อให้ได้กรดอะมิโนที่เหมาะสมต่อความต้องการของร่างกาย ในมุมมองของ Medical Wellness เป้าหมายไม่ได้อยู่ที่การเพิ่มโปรตีนเพียงอย่างเดียว แต่คือการสร้างสมดุลทางโภชนาการที่สามารถสนับสนุนสุขภาพในระยะยาว
เมื่ออายุมากขึ้น ร่างกายมีการเปลี่ยนแปลงทางสรีรวิทยาหลายด้าน เช่น การลดลงของมวลกล้ามเนื้อ, การเปลี่ยนแปลงของกระบวนการเผาผลาญ,
การฟื้นตัวของเนื้อเยื่อที่ช้าลง, ความต้องการสารอาหารที่เปลี่ยนไป การได้รับโปรตีนอย่างเหมาะสมจึงเป็นส่วนหนึ่งของแนวทางการดูแลสุขภาพเชิงป้องกัน
เพราะโปรตีนมีบทบาทสำคัญต่อการคงมวลกล้ามเนื้อ, การซ่อมแซมเนื้อเยื่อ, การสร้างเอนไซม์และฮอร์โมน, การสนับสนุนระบบภูมิคุ้มกัน, การช่วยคงคุณภาพชีวิตในระยะยาว
ในปัจจุบันผู้คนจำนวนมากเลือกโปรตีนพืชเป็นส่วนหนึ่งของ Lifestyle Wellness ด้วยเหตุผลหลัก ๆ เช่น
🧬Digestive-Friendly Approach ผู้ที่รับประทานโปรตีนบางชนิดอาจมีอาการไม่สบายทางเดินอาหาร เช่น ท้องอืด หรือแน่นท้อง
การเลือกโปรตีนที่เหมาะสมกับแต่ละบุคคลจึงเป็นสิ่งสำคัญ
📈Long-Term Nutritional Balance โปรตีนพืชบางชนิดมาพร้อมองค์ประกอบทางโภชนาการอื่น เช่น
ใยอาหาร, แร่ธาตุ, สารต้านอนุมูลอิสระ, สารพฤกษเคมี ที่อาจช่วยสนับสนุนรูปแบบการรับประทานอาหารที่สมดุล
🧘Lifestyle & Wellness Integration โปรตีนพืชได้รับความนิยมในกลุ่มผู้ที่ใส่ใจสุขภาพ, ผู้สูงอายุ, ผู้ที่ออกกำลังกาย,
ผู้ที่ต้องการดูแลสุขภาพในระยะยาว, ผู้ที่หลีกเลี่ยงผลิตภัณฑ์จากนม

Longevity Nutrition คือแนวคิดการดูแลสุขภาพผ่านโภชนาการที่มุ่งเน้นคุณภาพชีวิตในระยะยาว มีองค์ประกอบสำคัญประกอบด้วย

ควรเลือกผลิตภัณฑ์ที่มีปริมาณโปรตีนเพียงพอต่อหนึ่งหน่วยบริโภค

โปรตีนจากพืชหลายชนิดสามารถนำมาผสมกันเพื่อเพิ่มความสมดุลของกรดอะมิโน

ควรพิจารณาปริมาณน้ำตาล ปริมาณโซเดียม สารปรุงแต่งที่ไม่จำเป็น

ในแนวคิด Wellness การเลือกอาหารไม่ใช่เพียงสิ่งที่ให้ผลระยะสั้น แต่คือสิ่งที่สามารถรับประทานได้อย่างเหมาะสมในระยะยาว
Plant-Based Protein ไม่ได้เป็นเพียงทางเลือกของผู้รับประทานอาหารจากพืช แต่กำลังกลายเป็นส่วนหนึ่งของแนวทางการดูแลสุขภาพเชิงป้องกันและ Nutrition Wellness การเลือกโปรตีนที่เหมาะสม ควบคู่กับการดูแลสุขภาพแบบองค์รวม อาจช่วยสนับสนุนคุณภาพชีวิตและสุขภาวะในระยะยาว
บทความนี้จัดทำขึ้นเพื่อให้ข้อมูลด้านสุขภาพและการดูแลสุขภาพทั่วไป ไม่ใช้เพื่อการวินิจฉัย รักษา หรือป้องกันโรค ควรปรึกษาผู้เชี่ยวชาญสำหรับคำแนะนำเฉพาะบุคคล
ทำไมต้องเป็นโปรตีนพืช?
ในปัจจุบัน แนวคิดด้านสุขภาพได้เปลี่ยนจากการ “รักษาเมื่อเกิดโรค” ไปสู่ “การดูแลสุขภาพระยะยาว” หรือ Medical Wellness ซึ่งมุ่งเน้นการป้องกันความเสื่อมของร่างกายและส่งเสริมคุณภาพชีวิตในระยะยาว และหนึ่งในองค์ประกอบสำคัญคือ “โภชนาการ” โดยเฉพาะการได้รับโปรตีนอย่างเพียงพอ
โปรตีนพืชกินเวลาไหนดีที่สุด?
(คู่มือฉบับสมบูรณ์เพื่อผลลัพธ์สูงสุด)
คำถามนี้เป็นคำถามที่หลายคนสงสัยมาก โดยเฉพาะคนที่เริ่มดูแลสุขภาพ หรือกำลังมองหาอาหารเสริมที่ปลอดภัยต่อร่างกาย
วิธีเลือกโปรตีนพืชแบบมืออาชีพ เลือกยังไงให้ปลอดภัย เหมาะกับสุขภาพ ไม่เพิ่มน้ำหนักแต่เพิ่มกล้ามเนื้อ และไม่ทำร้ายไต อ่านจบเลือกเป็นทันที
🥗 วิธีเลือกโปรตีนพืช สำคัญกว่าที่คุณคิด ในยุคที่คนหันมาใส่ใจสุขภาพมากขึ้น “โปรตีนพืช” กลายเป็นหนึ่งในอาหารเสริมยอดนิยม แต่คำถามสำคัญคือ…
โปรตีนพืช กินเท่าไหร่ถึงพอดี?
คำว่า “พอดี” ของแต่ละคนอาจไม่เท่ากัน เนื่องจากร่างกายของแต่ละคนต่างกัน หรือแม้แต่ช่วงอายุ ไลฟ์สไตล์ โรคประจำตัวที่ต่างกัน ก็มีผลต่อปริมาณโปรตีนที่ร่างกายควรได้รับอย่างเพียงพอในแต่ละวันต่างกัน
แนวคิดด้านโภชนาการที่มุ่งเน้นการสนับสนุนสุขภาพระยะยาว ผ่านการรับสารอาหารอย่างเหมาะสม เพื่อช่วยดูแลสมดุลการทำงานของร่างกาย สนับสนุนการคงมวลกล้ามเนื้อ และส่งเสริมคุณภาพชีวิตในระยะยาว

Healthy Aging คือแนวคิดของการมีอายุที่เพิ่มขึ้นพร้อมกับการคงไว้ซึ่งคุณภาพชีวิต ความแข็งแรง และความสามารถในการใช้ชีวิตประจำวัน เป้าหมายไม่ใช่การ “หยุดอายุ” แต่เป็นการดูแลร่างกายให้สามารถทำงานได้อย่างเหมาะสมในระยะยาว โดยให้ความสำคัญกับการดูแลหลายองค์ประกอบร่วมกัน เช่น
– โภชนาการเฉพาะบุคคล
– การนอนหลับ
– การออกกำลังกาย
– การจัดการความเครียด
– การดูแลองค์ประกอบของร่างกาย
– พฤติกรรมสุขภาพระยะยาว
เมื่ออายุเพิ่มขึ้น ร่างกายอาจมีการเปลี่ยนแปลงหลายด้าน เช่น มวลกล้ามเนื้อลดลงตามวัย, ระบบเผาผลาญพลังงานเปลี่ยนแปลง, ความต้องการสารอาหารบางชนิดอาจเพิ่มขึ้น, การฟื้นตัวของร่างกายอาจช้าลง, ระดับพลังงานในแต่ละวันอาจลดลง
ดังนั้นการรับประทานอาหารในปริมาณเท่าเดิมอาจไม่ได้หมายถึงการได้รับสารอาหารที่เพียงพอเสมอไป เราจึงให้ความสำคัญกับแนวคิด “Nutrition Quality Over Quantity” หรือการให้ความสำคัญกับคุณภาพของสารอาหาร มากกว่าปริมาณอาหารเพียงอย่างเดียว
Read MoreHealthy Aging ไม่ได้เกิดจากอาหารเพียงอย่างเดียว แต่เกิดจากการดูแลสุขภาพแบบองค์รวม แนวทางที่แนะนำ ได้แก่
– ออกกำลังกายอย่างสม่ำเสมอ
– นอนหลับอย่างมีคุณภาพ
– จัดการความเครียด
– ดูแลมวลกล้ามเนื้อ
– รับประทานอาหารอย่างสมดุล
– ตรวจสุขภาพอย่างเหมาะสม
หลายคนคิดว่าการดูแลเรื่องการสูงวัยเป็นเรื่องของคนอายุ 60–70 ปีขึ้นไป แต่ความจริงแล้ว การเปลี่ยนแปลงหลายอย่างในร่างกายเริ่มเกิดขึ้นตั้งแต่วัยทำงาน การดูแลโภชนาการตั้งแต่วันนี้อาจเป็นการลงทุนเพื่อสุขภาพในระยะยาว
Healthy Aging ไม่ได้หมายถึงการพยายามย้อนวัย แต่คือการมีพลังงาน มีความแข็งแรง และใช้ชีวิตในแบบที่ต้องการได้นานขึ้น

Kidney-Friendly Nutrition หรือ “โภชนาการที่เป็นมิตรต่อไต”
คือแนวทางการกินอาหาร ที่ช่วยลดภาระการทำงานของไต ชะลอการเสื่อมของไต ป้องกันโรคไตในระยะยาว ซึ่งไตมีหน้าที่สำคัญในการกรองของเสียออกจากเลือด
ควบคุมสมดุลน้ำและแร่ธาตุ ควบคุมความดันโลหิต
ดังนั้น “สิ่งที่เรากิน” มีผลต่อไตโดยตรง
หลักการสำคัญของ Kidney-Friendly Nutrition คือ การควบคุม “โปรตีน” ให้เหมาะสม โปรตีนเป็นสารอาหารจำเป็น
แต่การกินมากเกินไปทำให้ไตต้องกรองของเสียมากขึ้น เกิดภาระต่อไต
โดยปริมาณที่แนะนำสำหรับคนทั่วไปคือ 0.8–1.0 g/kg หรือในผู้ที่มีภาวะไตพร่อง ต้องคิดตามระยะค่ากรองไต
แต่สิ่งหนึ่งที่สำคัญไม่ใช่แค่ “ปริมาณ” แต่คือ “คุณภาพของโปรตีน” ที่เราเสริมเข้าไป ว่าเป็นโปรตีนที่ได้มาจากอะไร
มีสารเติมแต่งอะไรนอกจากโปรตีน และมีปริมาณโซเดียมเท่าไหร่ อีกทั้งยังต้องคำนึงถึงระดับโซเดียมในอาหารแต่ละวันที่รับประทานเข้าไปด้วย ดังนั้นการเลือกโปรตีนที่ได้คุณภาพ จึงไม่เพิ่มภาระให้ร่างกายและไต

ในคนทั่วไปที่มีสุขภาพดี มีงานวิจัยจำนวนมากพบว่าการรับประทานโปรตีนในปริมาณที่เหมาะสม “ไม่ได้ทำให้ไตเสื่อม”
แต่อย่างไรก็ตาม การบริโภคโปรตีนในปริมาณสูงมากเป็นเวลานาน อาจทำให้ไตต้องทำงานมากขึ้น เนื่องจากต้องกรองของเสียจากการเผาผลาญโปรตีน
ส่วนผู้ที่มี “โรคไต” อยู่แล้ว แพทย์หรือผู้เชี่ยวชาญด้านโภชนาการมักแนะนำให้ควบคุมปริมาณโปรตีนตามความเหมาะสมของแต่ละบุคคล
การเลือกโปรตีนให้เหมาะสม ไม่ว่าจะเป็นโปรตีนพืชหรือโปรตีนจากสัตว์ สิ่งสำคัญคือการเลือกผลิตภัณฑ์ที่เหมาะกับการบริโภคในชีวิตประจำวัน ซึ่งผู้บริโภคจำนวนมากในปัจจุบันให้ความสำคัญกับปัจจัยต่าง ๆ เช่น
🔺ส่วนผสมที่เรียบง่าย
🔺ปริมาณโซเดียมที่ไม่สูงเกินไป
🔺ไม่เติมน้ำตาลเกินความจำเป็น
🔺เหมาะกับการรับประทานเป็นประจำ
การอ่านฉลากโภชนาการและส่วนผสมจึงเป็นสิ่งสำคัญในการเลือกผลิตภัณฑ์โปรตีน และถึงแม้โปรตีนเป็นสารอาหารสำคัญที่มีบทบาทต่อการทำงานของร่างกายในหลายระบบ ปริมาณและรูปแบบของโปรตีนที่เหมาะสมของแต่ละคนอาจแตกต่างกันไป โดยเฉพาะในผู้ที่มีภาวะสุขภาพจำกัด ดังนั้นการดูแลโภชนาการอย่างสมดุลและเหมาะสมกับร่างกายจึงเป็นพื้นฐานสำคัญของการดูแลสุขภาพในระยะยาว

🥗 1. ควบคุมอาหารอย่างเหมาะสม อาหารคือปัจจัยสำคัญที่สุด
👉 หลักการ: ลดเค็ม คุมโปรตีน เลี่ยงอาหารแปรรูป
🍽️ 2. กินโปรตีน “พอดี ไม่มากเกิน”
โปรตีนจำเป็นต่อร่างกาย แต่ถ้ามากเกินไป ไตจะต้องทำงานหนักขึ้น
📊 แนะนำ:ประมาณ 0.6–0.8 กรัม/น้ำหนักตัว (kg)
👉 ควรปรึกษาแพทย์เพื่อความแม่นยำ
🌱 3. เลือกโปรตีนที่ “เป็นมิตรต่อไต”
✅ แนะนำ: โปรตีนพืช เต้าหู้ ถั่ว (ในปริมาณเหมาะสม) เพราะสร้างของเสียน้อยกว่า ย่อยง่าย
🧂 4. ลดโซเดียม (เค็ม) โซเดียมสูงทำให้ความดันโลหิตสูง บวมน้ำ ไตทำงานหนัก
✔ คำแนะนำ:ไม่เกิน 2,000 mg/วัน และเลี่ยงอาหารสำเร็จรูป
💧 5. ดื่มน้ำให้เหมาะสม น้ำช่วยขับของเสีย แต่สำหรับผู้ป่วยไตต้อง “พอดี” ไม่มากหรือน้อยเกินไป
⚖️ 6. ควบคุมน้ำหนัก น้ำหนักเกินเพิ่มความเสี่ยงไตเสื่อม เพิ่มภาระร่างกาย
🏃♂️ 7. ออกกำลังกายสม่ำเสมอ ช่วยควบคุมความดัน ลดน้ำตาล เสริมสุขภาพโดยรวม
💊 8. ทานยาตามแพทย์สั่งอย่างเคร่งครัด
❗ ห้ามหยุดยาเอง
❗ หลีกเลี่ยงยาที่ทำร้ายไต เช่น ยาแก้ปวดบางชนิด
🚭 9. หลีกเลี่ยงพฤติกรรมเสี่ยง สูบบุหรี่ ดื่มแอลกอฮอล์ นอนน้อย
🩺 10. ตรวจสุขภาพสม่ำเสมอติดตามค่าการทำงานของไต ความดัน และระดับน้ำตาล

🌱 โปรตีนพืช: สร้างของเสียน้อยกว่า มีไฟเบอร์ ลดการอักเสบ
🥩 โปรตีนสัตว์:สร้างของเสียมากกว่า และอาจมีไขมันอิ่มตัว
👉 แนวโน้มงานวิจัย: Plant-Based Diet = ดีต่อไตมากกว่า
Plant-Based Diet คืออะไร?
Plant-Based Diet คือรูปแบบการกินที่เน้นอาหารจากพืชเป็นหลัก เช่น ผัก ผลไม้ ธัญพืช ถั่ว และเมล็ดพืช โดยลดหรือหลีกเลี่ยงอาหารจากสัตว์ 👉 จุดสำคัญคือ “กินพืชเป็นหลัก ไม่ใช่จำเป็นต้องงดสัตว์ 100%”
ยกตัวอย่างเช่น อาหารที่เน้นผักทุกชนิด ,ผลไม้ ,ธัญพืช (ข้าว กล้อง ควินัว ข้าวโอ๊ต) ,ถั่ว (ถั่วเหลือง ถั่วลันเตา อัลมอนด์) ,เมล็ดพืช (เมล็ดเจีย เมล็ดแฟลกซ์)
ส่วนอาหารที่ลด/เลี่ยง เช่นเนื้อสัตว์ ,อาหารแปรรูป ,ไขมันทรานส์,อาหารที่มีน้ำตาลสูง
ประโยชน์ของ Plant-Based Diet
❤️ 1. ดีต่อหัวใจ : ลดคอเลสเตอรอล ,ลดความดัน
🍬 2. ลดความเสี่ยงเบาหวาน : ควบคุมน้ำตาลในเลือด ,เพิ่มความไวอินซูลิน
🩺 3. ดีต่อไต : ลดภาระการทำงานของไต ,โปรตีนพืชสร้างของเสียน้อยกว่า
⚖️ 4. ช่วยควบคุมน้ำหนัก ,อิ่มนาน ,แคลอรี่ต่ำ
🌱 5. ชะลอวัย (Longevity) ,ลดการอักเสบ ,มีสารต้านอนุมูลอิสระ

กินอย่างไรให้ไตแข็งแรง ลดภาระไตในระยะยาว
Kidney-Friendly Diet คือรูปแบบการกินที่ออกแบบมาเพื่อลดภาระการทำงานของไต ,ควบคุมของเสียในร่างกาย ,ชะลอการเสื่อมของไต โดยเน้นการควบคุมสารอาหารสำคัญ เช่น โปรตีน ,โซเดียม ,โพแทสเซียม ,ฟอสฟอรัส จุดสำคัญคือ “ไม่ใช่แค่กินคลีน แต่ต้องกินให้เหมาะกับไต”
อาหารที่เหมาะกับ Kidney-Friendly Diet
🥦 1. ผักที่ดีต่อไต
🍎 2. ผลไม้ที่ปลอดภัย
🌾 3. ธัญพืช
🌱 4. โปรตีนที่เหมาะกับไต เช่น โปรตีนพืช ,เต้าหู้ ,ถั่ว (ในปริมาณพอดี)
หลักสำคัญที่ต้องคำนึงถึงคือ “โปรตีนต้องพอดี ไม่มากเกินไป”
🧠 วิธีจัดอาหารแบบ Kidney-Friendly
1.กินโปรตีนพอดี
2.ลดเค็ม
3.เลี่ยงอาหารแปรรูป
4.เน้นอาหารธรรมชาติ
ผู้บริโภคส่วนมากมักเข้าใจผิดเกี่ยวกับการทานอาหารในผู้ป่วยโรคไต เช่น
-คิดว่ากินคลีน = ดีต่อไตเสมอ
-คิดว่าต้องกินโปรตีนมากๆ
-ไม่ให้ความสำคัญกับปริมาณโซเดียม
ดังนั้น Kidney-Friendly Diet คือการกินที่ช่วยให้ไตทำงานเบาลงและแข็งแรงขึ้น

กินแบบไหนช่วยยืดอายุ ลดความเสี่ยงโรค และชะลอความเสื่อมของร่างกาย
พร้อมแนวทางโภชนาการเพื่อสุขภาพระยะยาว
รวม 10 อาหารที่ช่วยลดความเสื่อมของร่างกาย ชะลอวัย ลดการอักเสบ และเสริมสุขภาพระดับเซลล์ เหมาะสำหรับสาย Longevity และคนรักสุขภาพ
read moreรู้หรือไม่? พฤติกรรมการกินบางอย่างอาจทำให้คุณแก่เร็วและอายุสั้นลง รวม 5 พฤติกรรมที่ควรเลี่ยง พร้อมวิธีปรับเพื่อสุขภาพระยะยาว
หลายคนคิดว่าแค่ “ไม่ป่วย” = “สุขภาพดี” แต่ความจริงคือ ร่างกายกำลังเสื่อมลงทีละนิด จากสิ่งที่คุณกินทุกวัน เพราะพฤติกรรมการกินบางอย่างอาจไม่ได้ทำให้ป่วยทันที แต่จะ “สะสมผลเสีย” จนส่งผลในระยะยาว
read more
ในอดีต “การมีอายุยืน” อาจหมายถึงการมีชีวิตอยู่ให้นานที่สุดเท่าที่จะทำได้
แต่ในปัจจุบัน แนวคิดด้านสุขภาพระดับโลกกำลังเปลี่ยนไปสู่สิ่งที่สำคัญกว่า นั่นคือ
การมีชีวิตที่ยืนยาวจะไม่มีคุณค่าใด
หากร่างกายอ่อนล้า เจ็บป่วย หรือต้องใช้ชีวิตอย่างจำกัด
Autophagy กลไก “ล้างเซลล์เสีย” ที่ช่วยยืดอายุ
ในร่างกายของเรา มีระบบทำความสะอาดตัวเองที่ทรงพลังอยู่แล้วโดยธรรมชาติ เรียกว่า Autophagy (ออโตฟาจี) หรือ “กระบวนการกำจัดและรีไซเคิลเซลล์ที่เสื่อมสภาพ”
Inflammation ตัวการหลักของโรคเรื้อรัง
🔥 Inflammation: ตัวการลับของโรคเรื้อรังที่หลายคนมองข้าม
หลายคนคิดว่า “การอักเสบ” คือแค่ บวม แดง ร้อน เจ็บ แต่จริงๆ แล้ว การอักเสบเงียบ (Chronic inflammation) คือ “ต้นเหตุสำคัญ” ของโรคเรื้อรังแทบทุกชนิด
Oxidative Stress กับการแก่ของร่างกาย
ทำไมเราถึงแก่…ทั้งที่เรายังใช้ชีวิตเหมือนเดิม? เคยสงสัยไหมคะว่า ทำไมบางคนดูอ่อนวัยกว่าวัย ในขณะที่บางคนดูแก่เร็ว ทั้งๆ ที่อายุใกล้กัน หนึ่งในคำตอบสำคัญคือ
👉 “Oxidative Stress” หรือ ภาวะความเครียดจากอนุมูลอิสระ

11/1 Kosumruamjai 36 Donmuang, Donmuang ,Bangkok Thailand 10210

Office:
065-328 9959
Line Official ID : @mctc3259

support@medceutica.com